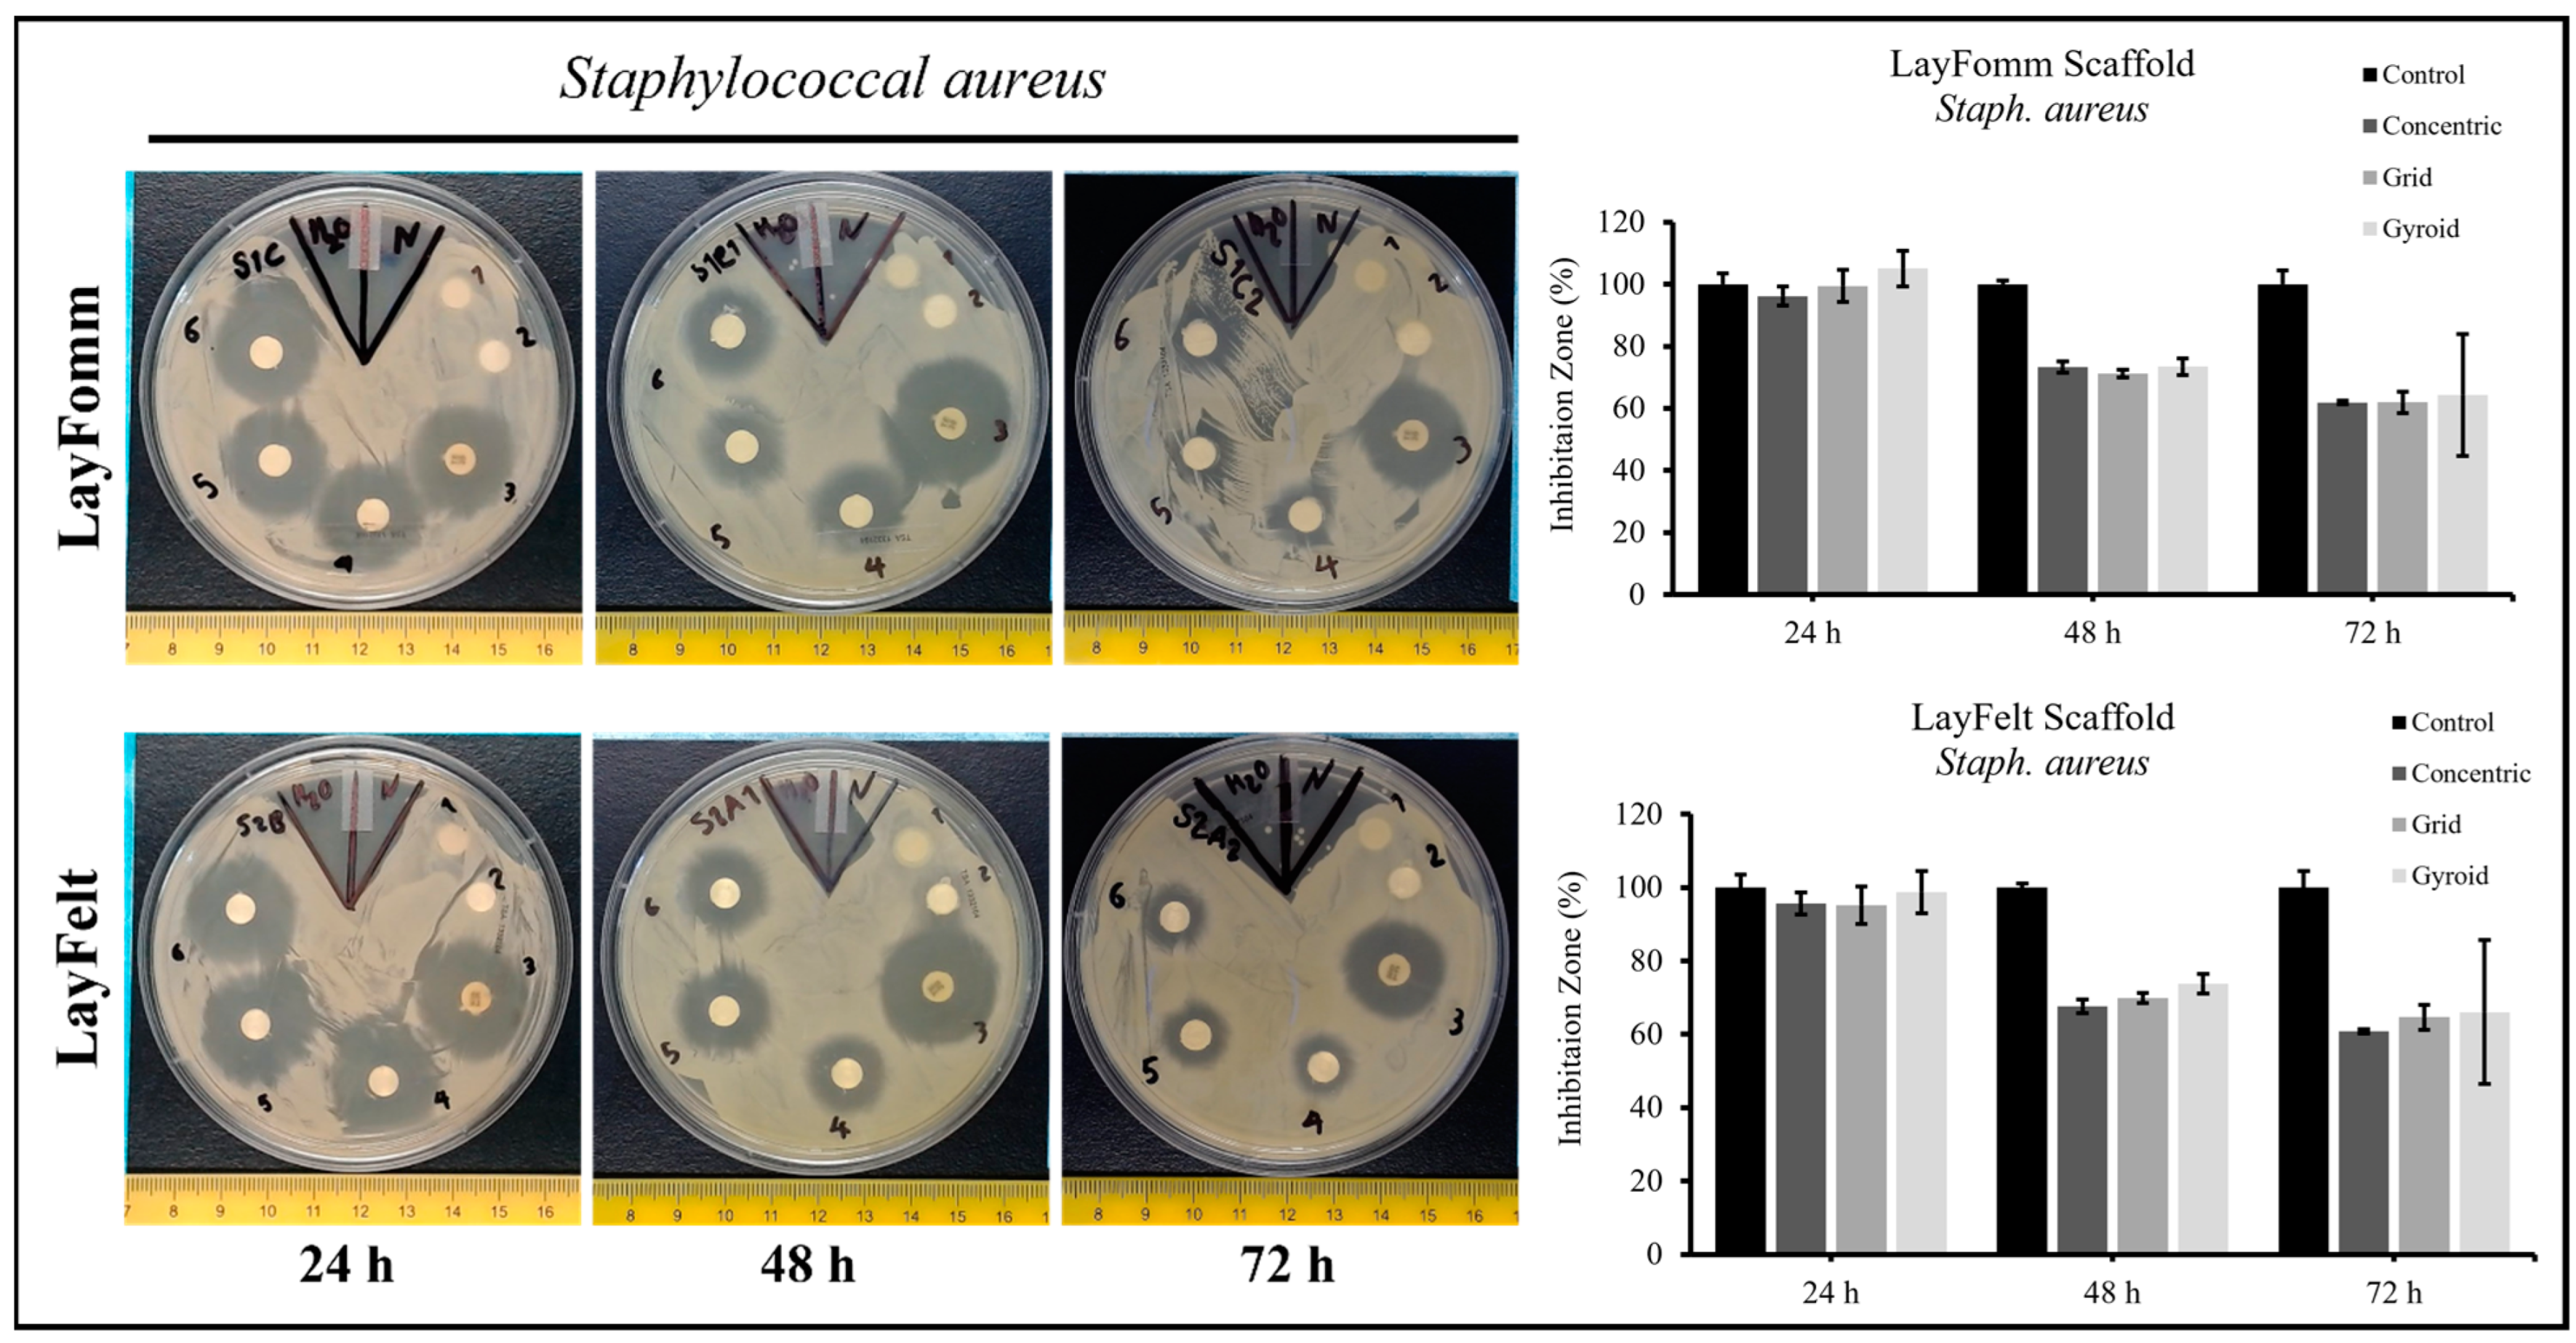
Micromachines 15 00083 g005
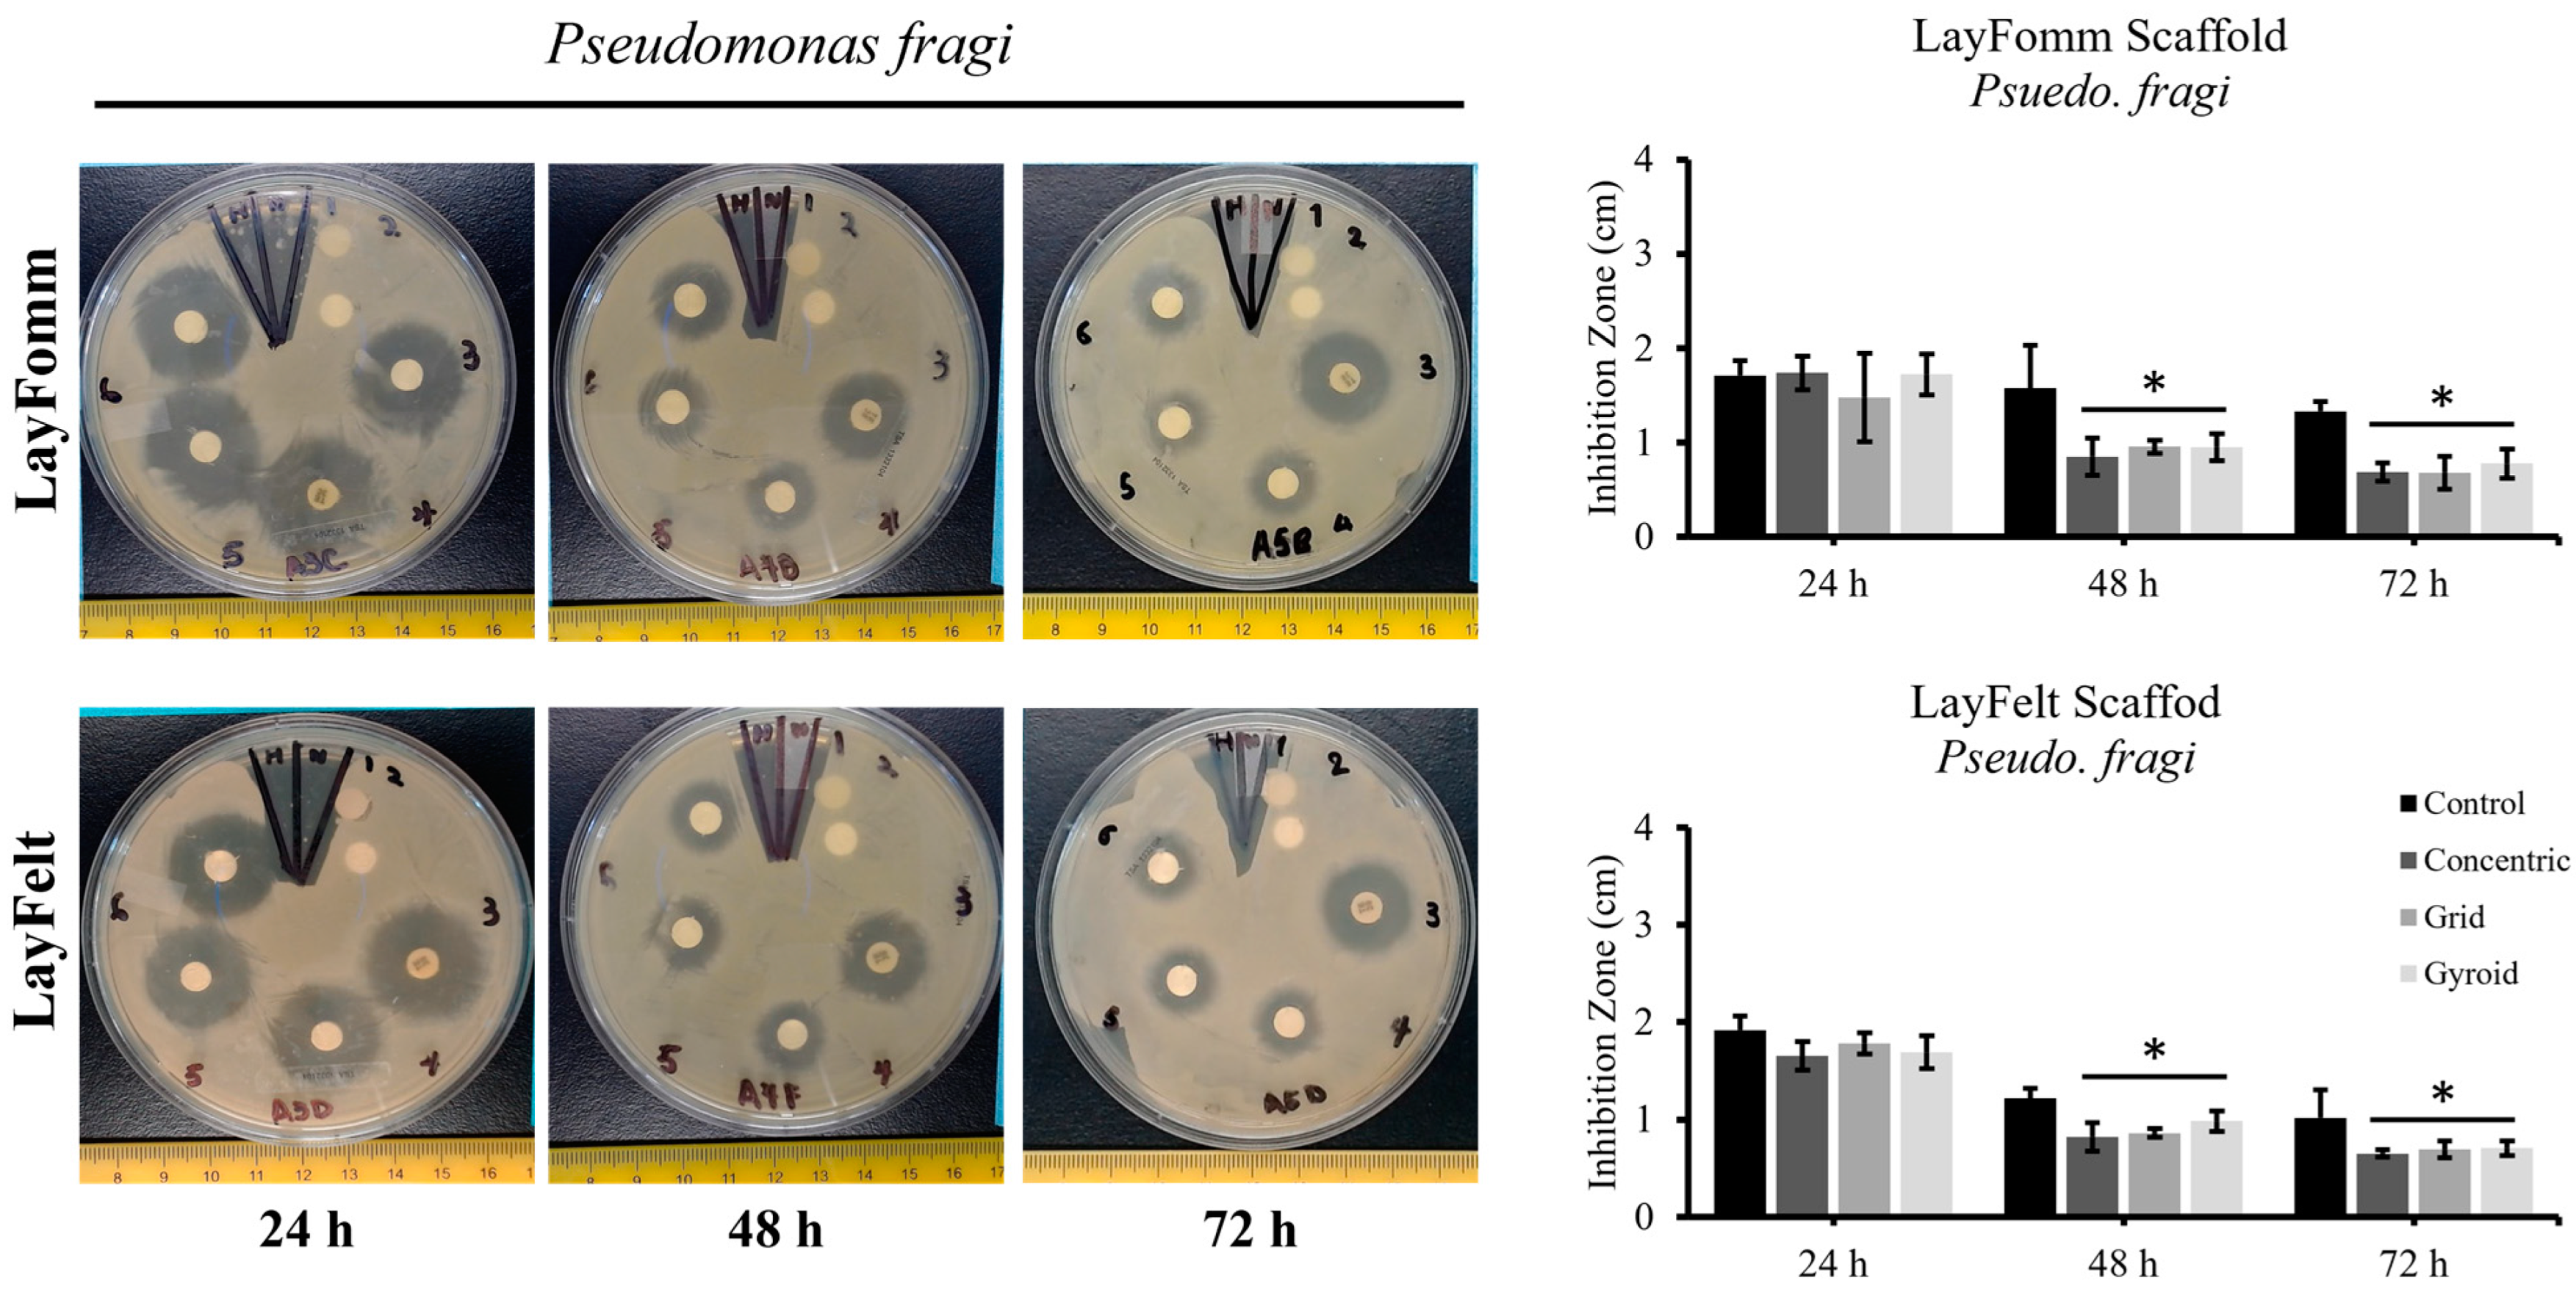
Micromachines 15 00083 g006

A Nanoporous 3D-Printed Scaffold for Local Antibiotic Delivery
Abstract
:1. Introduction
2. Materials and Methods
2.1. Three-Dimensional Printing of Disks
2.2. Scanning Electron Microscopy
2.3. Antibiotic Solution Preparation
2.4. Disk Sterilization and Loading
2.5. Agar Plate Preparation
2.6. Inhibition Zone Test Procedure
2.7. Metabolic Activity
2.8. Live/Dead Cell Viability Assay
3. Results
3.1. Filament Surface Analysis and Print Quality Control
3.2. Inhibition Zone Test
3.3. Metabolic Activity and Cell Viability
4. Discussion
Author Contributions
Funding
Data Availability Statement
Conflicts of Interest
References
- Roddy, E.; DeBaun, M.R.; Daoud-Gray, A.; Yang, Y.P.; Gardner, M.J. Treatment of critical-sized bone defects: Clinical and tissue engineering perspectives. Eur. J. Orthop. Surg. Traumatol. 2017, 28, 351–362. [Google Scholar] [CrossRef] [PubMed]
- Vidal, L.; Kampleitner, C.; Brennan, M.Á.; Hoornaert, A.; Layrolle, P. Reconstruction of Large Skeletal Defects: Current Clinical Therapeutic Strategies and Future Directions Using 3D Printing. Front. Bioeng. Biotechnol. 2020, 8, 61. [Google Scholar] [CrossRef] [PubMed]
- Ahangar, P.; Cooke, M.E.; Weber, M.H.; Rosenzweig, D.H. Current Biomedical Applications of 3D Printing and Additive Manufacturing. Appl. Sci. 2019, 9, 1713. [Google Scholar] [CrossRef]
- Schmidt, A.H. Autologous bone graft: Is it still the gold standard? Injury 2021, 52, S18–S22. [Google Scholar] [CrossRef] [PubMed]
- Ahangar, P.; Aziz, M.; Rosenzweig, D.H.; Weber, M.H. Advances in personalized treatment of metastatic spine disease. Ann. Transl. Med. 2019, 7, 223. [Google Scholar] [CrossRef] [PubMed]
- Masters, E.A.; Trombetta, R.P.; de Mesy Bentley, K.L.; Boyce, B.F.; Gill, A.L.; Gill, S.R.; Nishitani, K.; Ishikawa, M.; Morita, Y.; Ito, H.; et al. Evolving concepts in bone infection: Redefining “biofilm”, “acute vs. chronic osteomyelitis”, “the immune proteome” and “local antibiotic therapy”. Bone Res. 2019, 7, 20. [Google Scholar] [CrossRef] [PubMed]
- Fisichella, L.; Fenga, D.; Rosa, M.A. Surgical Site Infection in Orthopaedic Surgery: Correlation between Age, Diabetes, Smoke and Surgical Risk. Folia Medica 2014, 56, 259–263. [Google Scholar] [CrossRef]
- Manzini, B.M.; Machado, L.M.R.; Noritomi, P.Y.; da Silva, J.V.L. Advances in Bone tissue engineering: A fundamental review. J. Biosci. 2021, 46, 17. [Google Scholar] [CrossRef]
- Kantaros, A. 3D Printing in Regenerative Medicine: Technologies and Resources Utilized. Int. J. Mol. Sci. 2022, 23, 14621. [Google Scholar] [CrossRef]
- Kantaros, A.; Piromalis, D. Fabricating Lattice Structures via 3D Printing: The Case of Porous Bio-Engineered Scaffolds. Appl. Mech. 2021, 2, 289–302. [Google Scholar] [CrossRef]
- Visscher, L.E.; Dang, H.P.; Knackstedt, M.A.; Hutmacher, D.W.; Tran, P.A. 3D printed Polycaprolactone scaffolds with dual macro-microporosity for applications in local delivery of antibiotics. Mater. Sci. Eng. C 2018, 87, 78–89. [Google Scholar] [CrossRef] [PubMed]
- Sallent, I.; Capella-Monsonís, H.; Procter, P.; Bozo, I.Y.; Deev, R.V.; Zubov, D.; Vasyliev, R.; Perale, G.; Pertici, G.; Baker, J.; et al. The Few Who Made It: Commercially and Clinically Successful Innovative Bone Grafts. Front. Bioeng. Biotechnol. 2020, 8, 952. [Google Scholar] [CrossRef] [PubMed]
- Steadman, W.; Chapman, P.R.; Schuetz, M.; Schmutz, B.; Trampuz, A.; Tetsworth, K. Local Antibiotic Delivery Options in Prosthetic Joint Infection. Antibiotics 2023, 1, 752. [Google Scholar] [CrossRef] [PubMed]
- Wall, V.; Nguyen, T.-H.; Nguyen, N.; Tran, P.A. Controlling Antibiotic Release from Polymethylmethacrylate Bone Cement. Biomedicines 2021, 9, 26. [Google Scholar] [CrossRef] [PubMed]
- Kantaros, A. Bio-Inspired Materials: Exhibited Characteristics and Integration Degree in Bio-Printing Operations. Am. J. Eng. Appl. Sci. 2022, 15, 255–263. [Google Scholar] [CrossRef]
- Ahangar, P.; Akoury, E.; Ramirez Garcia Luna, A.S.; Nour, A.; Weber, M.H.; Rosenzweig, D.H. Nanoporous 3D-printed scaffolds for local doxorubicin delivery in bone metastases secondary to prostate cancer. Materials 2018, 11, 1485. [Google Scholar] [CrossRef]
- Akoury, E.; Weber, M.H.; Rosenzweig, D.H. 3D-Printed Nanoporous Scaffolds Impregnated with Zoledronate for the Treatment of Spinal Bone Metastases. MRS Adv. 2019, 4, 1245–1251. [Google Scholar] [CrossRef]
- Cook, T.S.; Zhang, J.; Starosolski, Z.; Ezon, D.S.; Krishnamurthy, R.; Dodd, N.; Heinle, J.; McKenzie, D.E.; Annapragada, A. Soft tissue models: Easy and inexpensive flexible 3D printing as a help in surgical planning of cardiovascular disorders. In Proceedings of the Medical Imaging 2017: Imaging Informatics for Healthcare, Research, and Applications, Orlando, FL, USA, 15–16 February 2017. [Google Scholar]
- Tsai, K.J.; Dixon, S.; Hale, L.R.; Darbyshire, A.; Martin, D.; de Mel, A. Biomimetic heterogenous elastic tissue development. npj Regen. Med. 2017, 2, 16. [Google Scholar] [CrossRef]
- Cui, M.; Chai, Z.; Lu, Y.; Zhu, J.; Chen, J. Developments of polyurethane in biomedical applications: A review. Resour. Chem. Mater. 2023, 2, 262–276. [Google Scholar] [CrossRef]
- Oberoi, G.; Nitsch, S.; Janjić, K.; Shokoohi-Tabrizi, H.; Moritz, A.; Moscato, F.; Unger, E.; Agis, H. The impact of 3D-printed LAY-FOMM 40 and LAY-FOMM 60 on L929 cells and human oral fibroblasts. Clin. Oral Investig. 2020, 25, 1869–1877. [Google Scholar] [CrossRef]
- Cooke, M.E.; Ramirez-GarciaLuna, J.L.; Rangel-Berridi, K.; Park, H.; Nazhat, S.N.; Weber, M.H.; Henderson, J.E.; Rosenzweig, D.H. 3D Printed Polyurethane Scaffolds for the Repair of Bone Defects. Front. Bioeng. Biotechnol. 2020, 8, 557215. [Google Scholar] [CrossRef] [PubMed]
- Abdul-Jabbar, A.; Takemoto, S.; Weber, M.H.; Hu, S.S.; Mummaneni, P.V.; Deviren, V.; Ames, C.P.; Chou, D.; Weinstein, P.R.; Burch, S.; et al. Surgical Site Infection in Spinal Surgery. Spine 2012, 37, 1340–1345. [Google Scholar] [CrossRef] [PubMed]
- Al Farii, H.; Slawaska-Eng, D.; Pankovitch, S.; Navarro-Ramirez, R.; Weber, M. Gram-Negative Surgical Site Infections After 989 Spinal Fusion Procedures: Associated Factors and the Role of Gram-Negative Prophylactic Antibiotic Coverage. Int. J. Spine Surg. 2021, 15, 341–347. [Google Scholar] [CrossRef] [PubMed]
- Salkind, A.R.; Rao, K.C. Antiobiotic prophylaxis to prevent surgical site infections. Am. Fam. Physician 2011, 83, 585–590. [Google Scholar] [PubMed]
- Lacombe, J.-G.; Cooke, M.E.; Park, H.; Alshammari, S.M.; Gawri, R.; Nazhat, S.N.; Martineau, P.A.; Rosenzweig, D.H. Primary Human Ligament Fibroblast Adhesion and Growth on 3D-Printed Scaffolds for Tissue Engineering Applications. Surgeries 2023, 4, 196–211. [Google Scholar] [CrossRef]
- Pitaru, A.A.; Lacombe, J.-G.; Cooke, M.E.; Beckman, L.; Steffen, T.; Weber, M.H.; Martineau, P.A.; Rosenzweig, D.H. 3D Printing to Microfabricate Stiff and Elastic Scaffolds that Mimic Ligament Tissue. Micromachines 2020, 11, 846. [Google Scholar] [CrossRef] [PubMed]
- You, J.; Preen, R.J.; Bull, L.; Greenman, J.; Ieropoulos, I. 3D printed components of microbial fuel cells: Towards monolithic microbial fuel cell fabrication using additive layer manufacturing. Sustain. Energy Technol. Assess. 2017, 19, 94–101. [Google Scholar] [CrossRef]
- Khan, Z.; He, H.; Chen, X.; Sydänheimo, L.; Ukkonen, L.; Virkki, J. Testing the effects of fabrication parameters on the post-fabrication shape change of a three-dimensional printed textile platform. Text. Res. J. 2021, 91, 2157–2166. [Google Scholar] [CrossRef]
- Parrado-Agudelo, J.Z.; Narváez-Tovar, C. Mechanical characterization of polylactic acid, polycaprolactone and Lay-Fomm 40 parts manufactured by fused deposition modeling, as a function of the printing parameters. Iteckne 2019, 16, 25–31. [Google Scholar] [CrossRef]
- Talalwa, L.; Natour, G.; Bauer, A.; Drzezga, A.; Beer, S. Radiological characteristics of a new experimental rubber elastomeric polymer used in three-dimensional printing with different infill densities and patterns. J. Phys. Commun. 2020, 4, 125006. [Google Scholar] [CrossRef]
- Stebbins, N.D.; Ouimet, M.A.; Uhrich, K.E. Antibiotic-containing polymers for localized, sustained drug delivery. Adv. Drug Deliv. Rev. 2014, 78, 77–87. [Google Scholar] [CrossRef] [PubMed]
- Palza, H.; Barraza, B.; Olate-Moya, F. An Overview for the Design of Antimicrobial Polymers: From Standard Antibiotic-Release Systems to Topographical and Smart Materials. Annu. Rev. Mater. Res. 2022, 52, 1–24. [Google Scholar] [CrossRef]
- Lewis, G.; Janna, S. Estimation of the optimum loading of an antibiotic powder in an acrylic bone cement: Gentamicin sulfate in SmartSet HV. Acta Orthop. 2009, 77, 622–627. [Google Scholar] [CrossRef] [PubMed]
- Klekamp, J.; Dawson, J.M.; Haas, D.W.; DeBoer, D.; Christie, M. The use of vancomycin and tobramycin in acrylic bone cement. J. Arthroplast. 1999, 14, 339–346. [Google Scholar] [CrossRef] [PubMed]
- Basak, P.; Adhikari, B.; Banerjee, I.; Maiti, T.K. Sustained release of antibiotic from polyurethane coated implant materials. J. Mater. Sci. Mater. Med. 2008, 20, 213–221. [Google Scholar] [CrossRef] [PubMed]
- Schierholz, J.M.; Steinhauser, H.; Rump, A.F.E.; Berkels, R.; Pulverer, G. Controlled release of antibiotics from biomedical polyurethanes: Morphological and structural features. Biomaterials 1997, 18, 839–844. [Google Scholar] [CrossRef] [PubMed]
- Jansen, B.; Schareina, S.; Treitz, U.; Peters, G.; Schumacher-Perdreau, F.; Pulverer, G. Antibiotic-Containing Polyurethanes for the Prevention of Foreign-Body Infections. In Progress in Biomedical Polymers; Springer: Berlin/Heidelberg, Germany, 1990; pp. 347–354. [Google Scholar] [CrossRef]
- Salimi, S.; Wu, Y.; Barreiros, M.I.E.; Natfji, A.A.; Khaled, S.; Wildman, R.; Hart, L.R.; Greco, F.; Clark, E.A.; Roberts, C.J.; et al. A 3D printed drug delivery implant formed from a dynamic supramolecular polyurethane formulation. Polym. Chem. 2020, 11, 3453–3464. [Google Scholar] [CrossRef]
- Fairag, R.; Li, L.; Ramirez-GarciaLuna, J.L.; Taylor, M.S.; Gaerke, B.; Weber, M.H.; Rosenzweig, D.H.; Haglund, L. A Composite Lactide-Mineral 3D-Printed Scaffold for Bone Repair and Regeneration. Front. Cell Dev. Biol. 2021, 9, 654518. [Google Scholar] [CrossRef]
- Inzana, J.A.; Trombetta, R.P.; Schwarz, E.M.; Kates, S.L.; Awad, H.A. 3D printed bioceramics for dual antibiotic delivery to treat implant-associated bone infection. Eur. Cells Mater. 2015, 30, 232–247. [Google Scholar] [CrossRef]
- Lee, J.-H.; Baik, J.-M.; Yu, Y.-S.; Kim, J.H.; Ahn, C.B.; Son, K.H.; Kim, J.-H.; Choi, E.S.; Lee, J.W. Development of a heat labile antibiotic eluting 3D printed scaffold for the treatment of osteomyelitis. Sci. Rep. 2020, 10, 7554. [Google Scholar] [CrossRef]
- Chen, J.-R.; Chen, J.-R.; Su, C.-K. Solution Foaming–Treated 3D-Printed monolithic packing for enhanced solid phase extraction of trace metals. Talanta 2022, 241, 123237. [Google Scholar] [CrossRef] [PubMed]
- Tan, M.L.; Zhang, M.; Li, F.; Maya, F.; Breadmore, M.C. A three-dimensional printed electromembrane extraction device for capillary electrophoresis. J. Chromatogr. A 2019, 1595, 215–220. [Google Scholar] [CrossRef] [PubMed]
- Kalsoom, U.; Hasan, C.K.; Tedone, L.; Desire, C.; Li, F.; Breadmore, M.C.; Nesterenko, P.N.; Paull, B. Low-Cost Passive Sampling Device with Integrated Porous Membrane Produced Using Multimaterial 3D Printing. Anal. Chem. 2018, 90, 12081–12089. [Google Scholar] [CrossRef] [PubMed]
- Su, C.-K.; Lin, J.-Y. 3D-Printed Column with Porous Monolithic Packing for Online Solid-Phase Extraction of Multiple Trace Metals in Environmental Water Samples. Anal. Chem. 2020, 92, 9640–9648. [Google Scholar] [CrossRef] [PubMed]
- Li, F.; Smejkal, P.; Macdonald, N.P.; Guijt, R.M.; Breadmore, M.C. One-Step Fabrication of a Microfluidic Device with an Integrated Membrane and Embedded Reagents by Multimaterial 3D Printing. Anal. Chem. 2017, 89, 4701–4707. [Google Scholar] [CrossRef] [PubMed]
- Flannagan, R.S.; Heit, B.; Heinrichs, D.E. Intracellular replication of Staphylococcus aureus in mature phagolysosomes in macrophages precedes host cell death, and bacterial escape and dissemination. Cell. Microbiol. 2016, 18, 514–535. [Google Scholar] [CrossRef] [PubMed]
- Kurow, O.; Nuwayhid, R.; Stock, P.; Steinert, M.; Langer, S.; Krämer, S.; Metelmann, I.B. Organotypic 3D Co-Culture of Human Pleura as a Novel In Vitro Model of Staphylococcus aureus Infection and Biofilm Development. Bioengineering 2023, 10, 537. [Google Scholar] [CrossRef]
- Ning, E.; Turnbull, G.; Clarke, J.; Picard, F.; Riches, P.; Vendrell, M.; Graham, D.; Wark, A.W.; Faulds, K.; Shu, W. 3D bioprinting of mature bacterial biofilms for antimicrobial resistance drug testing. Biofabrication 2019, 11, 045018. [Google Scholar] [CrossRef]
- Yeh, Y.-W.; Huang, C.-C.; Kuo, W.-S.; Liao, T.-L.; Tsai, T.-L.; Wu, P.-C. Multifunctional Hydrogel Dressing That Carries Three Antibiotics Simultaneously and Enables Real-Time Ultrasound Bacterial Colony Detection. ACS Omega 2023, 8, 10278–10287. [Google Scholar] [CrossRef]
- Nie, B.e.; Huo, S.; Qu, X.; Guo, J.; Liu, X.; Hong, Q.; Wang, Y.; Yang, J.; Yue, B. Bone infection site targeting nanoparticle-antibiotics delivery vehicle to enhance treatment efficacy of orthopedic implant related infection. Bioact. Mater. 2022, 16, 134–148. [Google Scholar] [CrossRef]
- Williams, D.L.; Kawaguchi, B.; Taylor, N.B.; Allyn, G.; Badham, M.A.; Rogers, J.C.; Peterson, B.R.; Sebahar, P.R.; Haussener, T.J.; Reddy, H.R.K.; et al. In vivo efficacy of a unique first-in-class antibiofilm antibiotic for biofilm-related wound infections caused by Acinetobacter baumannii. Biofilm 2020, 2, 100032. [Google Scholar] [CrossRef] [PubMed]

| Bacteria | Disks | 24 h | 48 h | 72 h |
| Staph. aureus | Control | 100 ± 1.9 | 100 ± 2.9 | 100 ± 1.9 |
| Concentric | 95.6 ± 5.7 | 67.7 ± 3.3 | 60.8 ± 2.9 | |
| Grid | 95.2 ± 4.3 | 69.9 ± 6.0 | 64.6 ± 2.7 | |
| Gyroid | 98.8 ± 1.8 | 73.8 ± 1.9 | 66.1 ± 2.6 | |
| Psuedo. fragi | Control | 100 ± 7.7 | 100 ± 8.4 | 100 ± 27.9 |
| Concentric | 91.1 ± 4.6 | 76.9 ± 29.8 | 68.7 ± 20.0 | |
| Grid | 96.9 ± 5.7 | 77.3 ± 18.3 | 71.4 ± 18.6 | |
| Gyroid | 92.9 ± 9.0 | 85.4 ± 17.8 | 72.0 ± 14.3 |
| Bacteria | Disks | 24 h | 48 h | 72 h |
| Staph. aureus | Control | 100 ± 3.6 | 100 ± 1.2 | 100 ± 4.5 |
| Concentric | 96.2 ± 3.0 | 73.3 ± 1.9 | 61.98 ± 0.6 | |
| Grid | 99.5 ± 5.1 | 71.2 ± 1.3 | 62.0 ± 3.5 | |
| Gyroid | 105.1 ± 5.8 | 73.5 ± 2.7 | 64.3 ± 19.7 | |
| Pseudo. fragi | Control | 100 ± 9.0 | 100 ± 28.9 | 100 ± 7.9 |
| Concentric | 101.5 ± 11.9 | 54.1 ± 12.8 | 51.4 ± 8.5 | |
| Grid | 86.4 ± 25.5 | 60.6 ± 17.3 | 51.1 ± 16.2 | |
| Gyroid | 100.7 ± 6.8 | 60.3 ± 12.1 | 58.4 ± 9.3 |
Disclaimer/Publisher’s Note: The statements, opinions and data contained in all publications are solely those of the individual author(s) and contributor(s) and not of MDPI and/or the editor(s). MDPI and/or the editor(s) disclaim responsibility for any injury to people or property resulting from any ideas, methods, instructions or products referred to in the content. |
© 2023 by the authors. Licensee MDPI, Basel, Switzerland. This article is an open access article distributed under the terms and conditions of the Creative Commons Attribution (CC BY) license (https://creativecommons.org/licenses/by/4.0/).
Share and Cite
Ahangar, P.; Li, J.; Nkindi, L.S.; Mohammadrezaee, Z.; Cooke, M.E.; Martineau, P.A.; Weber, M.H.; Saade, E.; Nateghi, N.; Rosenzweig, D.H. A Nanoporous 3D-Printed Scaffold for Local Antibiotic Delivery. Micromachines 2024, 15, 83. https://doi.org/10.3390/mi15010083
Ahangar P, Li J, Nkindi LS, Mohammadrezaee Z, Cooke ME, Martineau PA, Weber MH, Saade E, Nateghi N, Rosenzweig DH. A Nanoporous 3D-Printed Scaffold for Local Antibiotic Delivery. Micromachines. 2024; 15(1):83. https://doi.org/10.3390/mi15010083
Chicago/Turabian StyleAhangar, Pouyan, Jialiang Li, Leslie S. Nkindi, Zohreh Mohammadrezaee, Megan E. Cooke, Paul A. Martineau, Michael H. Weber, Elie Saade, Nima Nateghi, and Derek H. Rosenzweig. 2024. "A Nanoporous 3D-Printed Scaffold for Local Antibiotic Delivery" Micromachines 15, no. 1: 83. https://doi.org/10.3390/mi15010083
APA StyleAhangar, P., Li, J., Nkindi, L. S., Mohammadrezaee, Z., Cooke, M. E., Martineau, P. A., Weber, M. H., Saade, E., Nateghi, N., & Rosenzweig, D. H. (2024). A Nanoporous 3D-Printed Scaffold for Local Antibiotic Delivery. Micromachines, 15(1), 83. https://doi.org/10.3390/mi15010083








